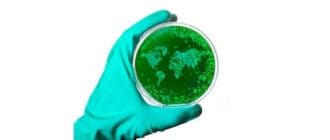

パンデミックは世界規模で発生しています。これは、細菌または新規ウイルスが急速に広がるようになると起こる。 重度の病気を引き起こし、ある人から次の人へと容易に広がります。 パンデミックという言葉は、「すべての人に関係する」 […]
Pilesは痔核の別の用語です。痔核は、肛門管内の炎症組織のコレクションです。それらは血管、支持組織、筋肉、および弾性繊維を含む。 多くの人が杭を持っていますが、その症状は必ずしも明らかではありません。痔核は、50歳未満 […]
恐怖症は、個人が状況、生き物、場所、または物体について極端で不合理な恐怖を経験するようにする不安障害の一種です。 人が恐怖症を抱えている場合、彼らは危険なものと思われるものを避けるために、しばしば人生を形作るでしょう。想 […]
レンズ豆は、マメ科植物の高タンパク、高繊維のメンバーである。豆のミニバージョンのように、レンズ豆はポッドで成長し、赤、茶、黒、緑の品種で来る。 彼らは乾燥した豆と比較して比較的迅速かつ容易に調製でき、その低コストにより、 […]
扁平苔癬は炎症性の皮膚状態であり、腕と脚にかゆみがあり、非感染性の発疹が特徴です。これは、小さな、多面、フラットトップ、ピンクまたは紫のバンプで構成されています。 かなりの数の皮膚専門医が自己免疫疾患であると信じています […]
プルーンジュースは一般的に便秘を緩和するために使用されますが、そのメリットはそこで止まらないのです。プルーンジュースには様々な健康上の利点があります。 プルーンがそれ自身の特定の果実であることはよくある誤解です。プルーン […]
レイキは一般的にエネルギー治癒と呼ばれる代替療法の一形態です。それは1800年代後半に日本で出現し、開業医の手のひらからその患者に普遍的なエネルギーを伝達することを含むと言われています。 エネルギーの癒しは何世紀にもわた […]
排卵は、女性の月経中の卵の放出を指す。 卵巣と呼ばれる卵巣の一部は卵を排出する。卵は、卵子、卵母細胞、または女性の配偶子としても知られています。それは満期到来時にのみリリースされます。 放出後、卵は卵管を通って移動し、そ […]
カリウムは、7つの必須のマクロミネラルの1つです。人体には、重要なプロセスをサポートするために、毎日少なくとも100ミリグラムのカリウムが必要です。 カリウム摂取量が多いと、全体の死亡率が20%低下します。また、脳卒中リ […]
腹膜炎は腹膜の障害である。これは胃の壁の内側の湿った組織です。この状態は、通常、細菌感染後に起こる。 すぐに治療が必要な深刻で緊急な症状です。症状には、突然の重度の腹痛が含まれる。 穿孔とも呼ばれる破裂は、しばしば感染を […]
口の潰瘍は口や歯肉の痛みを伴う部分です。彼らはまた、口内炎の痛みとして知られています。 ほとんど無害ですが、口腔潰瘍は非常に不快になり、一部の人々が食べたり、飲んだり、歯磨きしたりするのが難しくなります。 口の潰瘍の大き […]
足底の屈曲は、足が足を下ろし、足から離れるように足首の伸展を説明する。 立った姿勢では、足を床に向けて指すことになります。 足底屈曲は、静止位置から約20〜50度の正常な運動範囲を有する。 この記事では、足底屈曲が起こる […]
梨は、繊維質の中心部を有するマイルドで甘い果実です。彼らは重要な抗酸化物質、フラボノイド、食物繊維が豊富で、これらの栄養素はすべて、無脂肪、コレステロールフリー、100カロリーのパッケージにまとめられています。 消費する […]
乾癬は、乾燥した、赤い、鱗片状のパッチおよびフレークを皮膚に現す共通の慢性自己免疫疾患である。発疹はしばしば消えてしまいますが、しばしばストレスなどのトリガーの結果として再び発赤します。 これは、免疫系が誤って皮膚細胞を […]
閉経は、女性が肥沃または月経不能になる過程である。それは人生の通常の部分であり、病気または状態とはみなされません。 症状は、女性の最終期間の数年前に発生することがあります。一部の女性は、数か月後または数年後に症状を経験す […]
肺結節は肺の小さな成長である。肺結節とみなされるためには、成長は通常3センチメートル未満でなければならない。 肺結節は、非癌性または癌性とみなされる。非癌性結節は良性と呼ばれ、癌性肺結節は悪性腫瘍と呼ばれる。 3センチメ […]
心膜炎は、心臓を含む袋状の膜である心膜の炎症である。ほとんどの場合、病気は治療を受けなくなります。 多くの場合、心膜炎の原因は不明であるが、感染性または非感染性であり、心膜の最も一般的な疾患である。 この記事では、心膜炎 […]
陰茎骨折は、性交中に起こる稀で驚くべき傷害である。 陰茎骨折は、骨折の場合と同じではありません。代わりに、それは勃起の原因となる陰茎の2つの領域、すなわち、海綿体および陰茎鞘の破裂である。 傷害は、男性の性的機能および泌 […]
世界的には、マリファナ(大麻)が最も一般的に使用されている違法薬物です。 Schedule 1規制対象物質に分類されるマリファナは、身体のほとんどすべての臓器に作用する気分転換型(精神活性型)薬物です。 アンケート調査に […]
ロブスターは典型的には煮沸または蒸しにより調製される貝の一種である。メインコースとして食べることができ、サンドイッチ充填剤として楽しむことができ、パスタ、マッシュポテト、卵ベネディクトなどの豊富な料理に加えることができま […]
虫垂は、糸状虫としても知られ、非常に一般的な腸内寄生虫です。ピンワム感染に関連する病状は、腸球菌(enterobiasis)として知られている。 米国疾病予防予防センター(CDC)によると、虫垂炎は米国で最も一般的な種類 […]